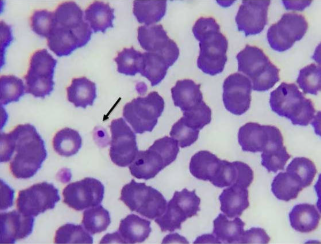

Para quem escolhe
excelência no seu
diagnóstico!
Somos um laboratório especializado em patologia clínica veterinária, atuando em parceria com o médico-veterinário para oferecer diagnósticos seguros, ágeis e responsáveis, o nosso foco é qualidade.


Qual a importância de escolher um laboratório de confiança?
O laboratório é uma extensão direta da conduta clínica, e resultados confiáveis exercem impacto direto no diagnóstico, no tratamento e no prognóstico do paciente. Muitos diagnósticos têm início no laboratório, a partir da identificação de achados microscópicos e alterações sutis, perceptíveis apenas quando há técnica, atenção e experiência. As imagens ilustram exemplos de achados no Lavet que foram decisivos para diagnósticos mais precisos e tratamentos mais assertivos.